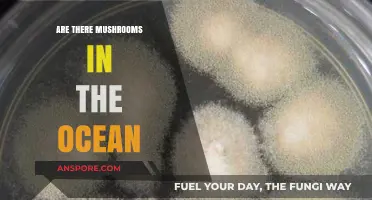
Exploring Ocean Fungi: Do Mushrooms Thrive in Marine Ecosystems?

Mushrooms have long puzzled scientists and enthusiasts alike due to their unique characteristics, which blur the lines between the plant and animal kingdoms. Unlike plants, mushrooms lack chlorophyll and do not produce their own food through photosynthesis, yet they also differ from animals as they do not move or consume other organisms for energy. Instead, mushrooms belong to the kingdom Fungi, a distinct group of organisms that play a crucial role in ecosystems by decomposing organic matter and forming symbiotic relationships with plants. Recent genetic studies have revealed that fungi are evolutionarily closer to animals than plants, sharing a common ancestor with animals over 1.5 billion years ago. This fascinating discovery challenges traditional classifications and highlights the intricate relationships within the tree of life, making mushrooms a captivating subject for exploration at the intersection of biology and evolution.
| Characteristics | Values |
|---|---|
| Kingdom | Fungi (separate from plants and animals) |
| Cell Walls | Chitin (like animals, unlike plants' cellulose) |
| Nutrient Acquisition | Absorb nutrients (like animals) vs. photosynthesis (plants) |
| Mobility | Stationary (like plants) vs. motile (some animals) |
| Respiration | Aerobic (like animals and plants) |
| Reproduction | Spores (unique to fungi, unlike seeds in plants or eggs in animals) |
| Evolutionary Lineage | Closer to animals (shared ancestor ~1.5 billion years ago) than plants (~1.1 billion years ago) |
| Energy Source | Heterotrophic (like animals) vs. autotrophic (plants) |
| Tissue Structure | Simple (like plants) vs. complex (animals) |
| Genetic Similarity | More genes in common with animals than plants |
Explore related products
What You'll Learn
- Taxonomic Classification: Mushrooms belong to Fungi kingdom, separate from Plantae and Animalia
- Cell Structure: Fungal cells have chitin, like animals, not cellulose like plants
- Nutrient Acquisition: Mushrooms absorb nutrients externally, similar to animals, not via photosynthesis
- Evolutionary Lineage: Fungi share a closer evolutionary ancestor with animals than plants
- Genetic Similarities: Mushrooms share more genes with animals, particularly in metabolism and signaling

Taxonomic Classification: Mushrooms belong to Fungi kingdom, separate from Plantae and Animalia
Mushrooms, often mistaken for plants due to their stationary nature and growth from the ground, are actually part of the Fungi kingdom, a taxonomic classification entirely separate from both Plantae and Animalia. This distinction is rooted in fundamental biological differences that set fungi apart from plants and animals. Unlike plants, fungi do not contain chlorophyll and cannot perform photosynthesis, the process by which plants convert sunlight into energy. Instead, fungi obtain nutrients by decomposing organic matter or forming symbiotic relationships with other organisms, a characteristic that aligns them more closely with heterotrophic modes of nutrition.
The cell walls of fungi are another key differentiator. While plant cell walls are primarily composed of cellulose, fungal cell walls are made of chitin, a substance also found in the exoskeletons of arthropods like insects and crustaceans. This chitinous composition is a hallmark of the Fungi kingdom and further distances mushrooms from plants. Additionally, fungi reproduce through spores, not seeds or pollen, and their growth patterns—such as mycelial networks—are unique to their kingdom. These structural and functional differences underscore why mushrooms are classified separately from plants.
When comparing mushrooms to animals, the distinctions are equally pronounced. Animals are multicellular, heterotrophic organisms that ingest their food, whereas fungi secrete enzymes to break down organic material externally before absorbing the nutrients. Animals also have specialized tissues and organs, a feature absent in fungi, which have a simpler, filamentous structure. Furthermore, the evolutionary lineage of fungi diverged from animals over a billion years ago, leading to distinct genetic and metabolic pathways. For instance, fungi share a closer evolutionary relationship with animals than with plants, as evidenced by molecular studies, but they remain a distinct kingdom due to their unique traits.
Taxonomically, the Fungi kingdom is one of the five primary kingdoms of life, alongside Plantae, Animalia, Protista, and Monera (or Bacteria and Archaea in modern classifications). This classification reflects the profound differences in cellular organization, metabolism, and reproductive strategies among these groups. Mushrooms, as fungi, occupy a unique ecological niche as decomposers and symbionts, playing a critical role in nutrient cycling and ecosystem health. Their placement in the Fungi kingdom highlights their distinct identity and dispels the misconception that they are closely related to plants or animals.
In summary, the taxonomic classification of mushrooms within the Fungi kingdom is based on clear biological distinctions from both plants and animals. Their inability to photosynthesize, chitinous cell walls, spore-based reproduction, and heterotrophic lifestyle set them apart from plants, while their external digestion, lack of specialized organs, and evolutionary history differentiate them from animals. Understanding these differences is essential for appreciating the diversity of life and the unique role fungi play in the natural world.
Mushroom Hunting: Foraging for Wild Fungi
You may want to see also

Cell Structure: Fungal cells have chitin, like animals, not cellulose like plants
When exploring the question of whether mushrooms are closer to animals or plants, one of the most revealing aspects is their cell structure. Unlike plant cells, which are primarily composed of cellulose in their cell walls, fungal cells, including those of mushrooms, contain chitin. Chitin is a tough, polysaccharide material that is also found in the exoskeletons of arthropods, such as insects and crustaceans, and in the cell walls of fungi. This fundamental difference in cell wall composition is a key factor in classifying fungi as distinct from plants. Cellulose, the main component of plant cell walls, provides rigidity and structural support, but chitin serves a similar purpose in fungi while also offering unique properties that align more closely with animal biology.
The presence of chitin in fungal cells is a significant indicator of their evolutionary divergence from plants. While both fungi and plants are eukaryotic organisms, their cell walls reflect different adaptations to their environments. Plants use cellulose to maintain their structure and support photosynthesis, whereas fungi use chitin to provide flexibility and resilience, which is essential for their role as decomposers and their ability to penetrate substrates like soil and organic matter. This distinction in cell wall composition highlights that fungi, including mushrooms, are not simply a subset of the plant kingdom but belong to a separate kingdom, Fungi, with unique characteristics.
Another critical point is that the presence of chitin in fungal cells aligns them more closely with animals than with plants in terms of biochemical composition. Animals, though lacking cell walls, use chitin in various structural roles, such as in the exoskeletons of insects and the beaks of cephalopods. This shared use of chitin suggests a closer evolutionary relationship between fungi and animals compared to plants. Furthermore, fungi and animals are both heterotrophs, meaning they obtain their nutrients by consuming organic matter, whereas plants are autotrophs, producing their own food through photosynthesis. This metabolic similarity, combined with the chitinous cell walls, reinforces the idea that mushrooms are more closely related to animals than to plants.
From a structural perspective, the chitin in fungal cell walls also influences their growth and behavior. Unlike the rigid, cellulose-based structure of plants, chitin allows fungal cells to grow in a more dynamic and invasive manner. This is evident in the way mushrooms and other fungi can penetrate and decompose organic materials, a function that is more akin to the digestive processes of animals. The flexibility provided by chitin enables fungi to adapt to diverse environments, from soil to decaying wood, further distinguishing them from the stationary, cellulose-dependent lifestyle of plants.
In summary, the cell structure of fungi, characterized by chitinous cell walls, is a defining feature that sets them apart from plants and aligns them more closely with animals. While plants rely on cellulose for structural support, fungi use chitin, a material also found in animal exoskeletons. This biochemical similarity, combined with shared heterotrophic traits, underscores the evolutionary divergence of fungi from plants and their closer relationship to animals. Understanding this distinction in cell structure is essential for grasping why mushrooms and other fungi belong to a unique kingdom in the biological classification system.
The Best Way to Store Chanterelle Mushrooms
You may want to see also

Nutrient Acquisition: Mushrooms absorb nutrients externally, similar to animals, not via photosynthesis
Mushrooms, often mistaken for plants due to their stationary nature, actually share a more intriguing similarity with animals when it comes to nutrient acquisition. Unlike plants, which harness sunlight through photosynthesis to produce energy, mushrooms lack chlorophyll and cannot synthesize their own food in this manner. Instead, they rely on external sources for their nutritional needs, a process that aligns more closely with animal behavior. This fundamental difference in nutrient acquisition is a key factor in understanding why mushrooms are classified in the kingdom Fungi, separate from both plants and animals.
The mechanism by which mushrooms obtain nutrients is through absorption, a process that mirrors how animals acquire sustenance. Mushrooms secrete enzymes into their environment, typically soil or decaying organic matter, to break down complex organic materials into simpler forms. These enzymes decompose substances like cellulose, lignin, and other organic compounds, releasing nutrients such as nitrogen, phosphorus, and carbon. The mushroom then absorbs these nutrients directly through its hyphae, the thread-like structures that make up the fungus's body. This external digestion and absorption process is strikingly similar to how animals ingest and break down food in their digestive systems.
In contrast, plants have evolved a completely different strategy for nutrient acquisition. They utilize photosynthesis, a process that converts sunlight, carbon dioxide, and water into glucose and oxygen. This internal production of energy allows plants to thrive in environments where organic matter is scarce. Mushrooms, however, are heterotrophs, meaning they must obtain their energy from pre-existing organic sources. This reliance on external nutrients places them in a category distinct from autotrophic plants, which are self-sustaining in terms of energy production.
The evolutionary implications of this nutrient acquisition method are profound. Mushrooms' ability to break down and absorb complex organic materials plays a crucial role in ecosystems as decomposers. They recycle nutrients from dead and decaying matter, returning essential elements to the soil and supporting the growth of other organisms. This function is more akin to the role of certain animals, such as detritivores, which also break down organic material. In this way, mushrooms act as a bridge between the living and the dead, facilitating the nutrient cycle in a manner that neither plants nor animals can replicate.
Furthermore, the external absorption of nutrients by mushrooms highlights their unique evolutionary path. While animals have developed specialized organs for ingestion and digestion, and plants have perfected the art of photosynthesis, mushrooms have carved out a niche by mastering the decomposition and absorption of organic matter. This specialization allows them to thrive in diverse environments, from forest floors to decaying logs, where they can access the nutrients they need. Their ability to adapt to various ecological niches underscores the efficiency and effectiveness of their nutrient acquisition strategy, which is fundamentally different from that of plants and shares more functional similarities with animals.
In summary, the way mushrooms acquire nutrients—externally, through absorption and decomposition—positions them closer to animals than to plants in terms of nutritional strategy. This distinction is not merely a biological curiosity but a critical aspect of their ecological role and evolutionary success. By understanding how mushrooms obtain their nutrients, we gain deeper insights into their unique place in the natural world and their importance in maintaining ecosystem health.
Psychedelics: MDMA and Mushrooms Explored
You may want to see also
Explore related products

Evolutionary Lineage: Fungi share a closer evolutionary ancestor with animals than plants
The question of whether mushrooms are closer to animals or plants has intrigued biologists for centuries. While mushrooms, as part of the kingdom Fungi, might superficially resemble plants due to their stationary nature, evolutionary biology reveals a different story. Fungi share a closer evolutionary ancestor with animals than with plants, a fact supported by molecular and genetic evidence. This surprising relationship is rooted in the shared characteristics and evolutionary pathways of Fungi and Animalia, which diverge significantly from those of Plantae.
One of the most compelling pieces of evidence for this closer relationship lies in the structure of cell walls. Plants have cell walls composed primarily of cellulose, a complex carbohydrate. In contrast, fungi have cell walls made of chitin, a tough polysaccharide also found in the exoskeletons of arthropods (a group of animals including insects and crustaceans). Animals, while lacking cell walls, share with fungi the presence of chitin in certain structures, highlighting a common biochemical heritage. This shared use of chitin is a strong indicator that fungi and animals branched off from a common ancestor after plants had already diverged.
Further evidence comes from the way fungi and animals obtain nutrients. Both groups are heterotrophs, meaning they must acquire organic compounds from external sources. Fungi achieve this by secreting enzymes to break down organic matter and then absorbing the nutrients, a process similar to how animals digest food internally. Plants, on the other hand, are autotrophs, producing their own food through photosynthesis. This fundamental difference in metabolism underscores the closer evolutionary ties between fungi and animals, as both have evolved mechanisms to process external organic material.
Genetic studies have provided additional support for the closer relationship between fungi and animals. Analyses of ribosomal RNA and other genetic markers have consistently placed Fungi and Animalia in a shared clade, known as the opisthokonts, which excludes plants. This grouping is based on shared genetic sequences and cellular structures, such as flagellar organization, that are absent in plants. The opisthokont lineage suggests that fungi and animals share a more recent common ancestor than either does with plants, reinforcing their evolutionary proximity.
Finally, the evolutionary history of multicellularity in fungi and animals further highlights their shared lineage. Both groups independently evolved complex multicellular forms from unicellular ancestors, a process that involved similar genetic and developmental mechanisms. In contrast, plants developed multicellularity through a different pathway, involving cell wall modifications and specialized tissues for photosynthesis. This parallel evolution of complexity in fungi and animals, distinct from plants, is a testament to their closer evolutionary relationship.
In summary, the evolutionary lineage of fungi reveals a closer kinship with animals than with plants. Shared traits such as chitin-based cell walls, heterotrophic nutrition, genetic similarities, and parallel evolutionary pathways all point to a common ancestor that fungi and animals share to the exclusion of plants. This understanding not only clarifies the position of fungi in the tree of life but also highlights the intricate connections between seemingly disparate organisms.
Mushroom Protein Power: How Much Is There?
You may want to see also

Genetic Similarities: Mushrooms share more genes with animals, particularly in metabolism and signaling
Mushrooms, often mistaken for plants due to their stationary nature, are actually part of the kingdom Fungi, which is genetically more closely related to animals than plants. This surprising relationship is revealed through genetic studies that compare the DNA sequences of fungi, plants, and animals. One of the most striking findings is that mushrooms share a greater number of genes with animals, particularly in areas related to metabolism and cellular signaling. These shared genes are involved in fundamental biological processes, such as breaking down nutrients and communicating between cells, which are essential for survival in both fungi and animals.
The genetic similarities between mushrooms and animals are especially evident in metabolic pathways. For instance, both fungi and animals are heterotrophs, meaning they obtain their energy by consuming organic matter rather than producing it through photosynthesis like plants. This shared metabolic strategy is reflected in their genes, where fungi and animals possess similar enzymes and pathways for breaking down complex molecules like sugars, fats, and proteins. In contrast, plants have distinct metabolic genes tailored to their photosynthetic lifestyle, which fungi and animals lack.
Cellular signaling is another area where mushrooms and animals exhibit remarkable genetic parallels. Both groups rely on intricate signaling networks to coordinate growth, development, and responses to their environment. For example, fungi and animals share genes involved in the production and reception of signaling molecules like G-proteins and kinases, which are crucial for processes such as cell division and immune responses. These shared signaling mechanisms highlight a common evolutionary heritage that diverges significantly from the signaling pathways found in plants.
At the molecular level, the genetic code of mushrooms also reveals closer ties to animals. Both fungi and animals have chitin in their cell walls or exoskeletons, a feature absent in plants, which use cellulose. The genes responsible for synthesizing chitin are more similar between fungi and animals than they are to any plant genes. Additionally, the structure and function of genes involved in protein synthesis and DNA repair show greater homology between fungi and animals, further reinforcing their genetic kinship.
These genetic similarities are not merely coincidental but are rooted in evolutionary history. Fungi and animals are believed to share a common ancestor that lived over a billion years ago, predating the divergence of plants. This shared ancestry explains why mushrooms and animals have retained more genetic commonalities in metabolism and signaling compared to plants. Understanding these genetic ties not only clarifies the taxonomic position of fungi but also provides insights into the evolutionary processes that shaped life on Earth. In summary, the genetic evidence overwhelmingly supports the idea that mushrooms are closer to animals than plants, particularly in the critical areas of metabolism and cellular signaling.
Death Cap Mushrooms: A Quick and Deadly Poison
You may want to see also
Frequently asked questions
Mushrooms are neither plants nor animals. They belong to the kingdom Fungi, which is a separate group of organisms distinct from both plants and animals.
Mushrooms are not considered plants because they lack chlorophyll and cannot perform photosynthesis. Instead, they obtain nutrients by decomposing organic matter or forming symbiotic relationships with other organisms.
Mushrooms share more genetic similarities with animals than with plants. Both fungi and animals are part of the opisthokont clade, which suggests a closer evolutionary relationship between them compared to plants.